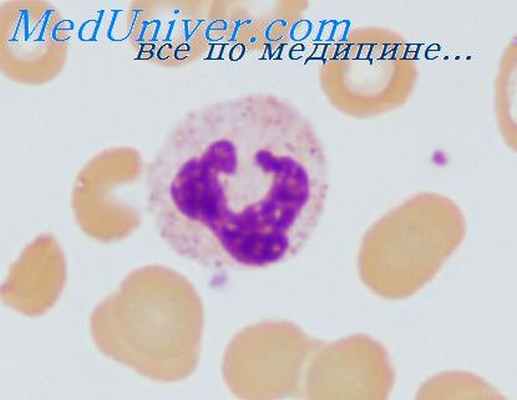
пищевые аллергены

Плесень как аллерген. Пищевые аллергены
Добавил пользователь Morpheus Обновлено: 05.01.2026
Penicillium chrysogenum (Penicillium notatum). Голубовато-зеленая плесень Penicillium notatum может присутствовать на черством хлебе, яблоках, апельсинах, сушеных фруктах, орехах. Она используется в производстве сыров с голубой и зеленой плесенью. Penicillium notatum можно обнаружить во влажном сене, в хранящемся зерне, темных влажных помещениях. Обладает выраженными антигенными свойствами. И споры, и мицелий этого гриба образуются круглогодично, активнее зимой. Легко переносятся воздухом и попадают в дыхательные пути, что при наличии предрасполагающих факторов приводит к развитию аллергических заболеваний. Клинические проявления включают аллергический ринит, астму, атопический дерматит. Некоторые подвиды этой плесени используют для производства пенициллина. Часто в анамнезе наблюдаются аллергические реакции на введение антибиотиков пенициллинового ряда. Тем не менее, аллергия на Penicillium notatum не подразумевает аллергию на пенициллин.
Cladosporium herbarum. Плесень Cladosporium herbarum размножается на многих органических субстратах, в том числе на деревьях, бумаге, опавших листьях, в грибницах, продуктах питания, текстиле. Обладает выраженными антигенными свойствами и является одним из наиболее распространенных респираторных аллергенов. Споры образуются весной, летом и осенью, легко переносятся воздухом и попадают в дыхательные пути, что при наличии предрасполагающих факторов приводит к развитию бронхиальной астмы (превалирует), ринита. Описаны случаи развития пневмонита. Иммунный ответ на этот аллерген развивается, главным образом, по немедленному типу с участием специфических IgE антител.
Aspergillus fumigatus. Плесень Aspergillus fumigatus встречается чаще на плодах граната, томатов, корнеплодах моркови, зерне с механическими повреждениями и трещинами. В местах поражения поверхность плода или зерна загнивает и покрывается пушистым черным налетом плесени. Налет состоит из грибницы темного цвета и многоклеточных спор. Образует токсин, оказывающий гемолитическое и антигенное действия. Сильный аллерген. Особую форму взаимодействия гриба и организма представляет бронхиальная астма, аллергический бронхолегочный аспергиллез. Так же, как и в случае с пыльцой, число спор в единице объема воздуха зависит от погодных условий и времени года (максимальные концентрации отмечаются поздним летом и ранней осенью).
Candida albicans. Грибковая плесень Candida albicans размножается на разных органических субстратах. Ее можно обнаружить в мусоре органического происхождения, в почве, в составе сапрофитной флоры носоглотки, в фекалиях человека. Этот вид может быть возбудителем клинически значимых инфекций человека: «молочницы» (одной из причин бактериального вагиноза), негонорейного уретрита, пневмонии у новорожденных, гнойных заболеваний, стоматита, системного кандидоза (монилиаза), кожной инфекции у лиц с диабетом и пр., что делает сложным оценку реакций гиперчувствительности. Роль Candida в качестве причины аллергии активно оспаривалась, хотя присутствие специфических IgE к Candida albicans описано при астме, рините, конъюнктивите.
Alternaria alternata (Alternaria tenuis). Плесневый гриб Alternaria tenuis (черная гниль) обычно черного цвета, поражает многие растительные и другие субстраты, включая продукты и текстиль. Черные пятна на томатах могут быть связаны с этой плесенью. Благоприятной средой обитания являются почва, прогнившая древесина, силос, компост. Наиболее опасными периодами являются лето и ранняя осень, когда наиболее активно образуются споры грибка. Местами обитания в квартирах могут быть влажные ванные и душевые комнаты, оттоки для конденсата кондиционеров. Это один из важнейших аллергенных компонентов домашней пыли, частая причина аллергии у детей. Является возбудителем болезни (альтернариоз). Чувствительность к Alternaria tenuis является фактором риска развития, поддержания и обострения астмы. Клиническими проявлениями аллергических реакций может быть ринит, иногда – пневмониты, при контакте компонентов гриба с кожей – атопическая экзема.
Setomelanomma rostrata (Helminthosporium halodes). Эта плесень является сезонным источником аллергенов, споры высвобождаются в сухие жаркие дни. Видами Helminthosporium нередко бывают заражены зерна, травы, сахарный тростник, почва, текстиль.
Сенсибилизация к аллергенам плесени может служить фактором риска развития, поддержания и обострения астмы. Диагноз наличия аллергии устанавливают на основании клинических симптомов, с учетом анамнеза пациента. Показания к назначению исследования: при наличии аллергоподобных симптомов (кашель, свистящее дыхание, ринит, конъюнктивит, экзема) в целях скрининга для подтверждения/исключения наличия сенсибилизации к аллергенам наиболее распространенных плесневых грибов.
Литература
Предпочтительно выдержать 4 часа после последнего приема пищи, обязательных требований нет. Антигистаминные препараты не оказывают влияния на результат. Исследование нежелательно проводить на фоне применения препаратов глюкокортикоидных гормонов (следует проконсультироваться с лечащим аллергологом по поводу целесообразности проведения исследования или условий отмены соответствующего препарата).
Литература
при наличии аллергоподобных симптомов (кашель, свистящее дыхание, ринит, конъюнктивит, экзема) в целях скрининга для подтверждения/исключения наличия сенсибилизации к аллергенам наиболее распространенных плесневых грибов.
Литература
Интерпретация результатов исследования содержит информацию для лечащего врача и не является диагнозом. Информацию из этого раздела нельзя использовать для самодиагностики и самолечения. Точный диагноз ставит врач, используя как результаты данного обследования, так и нужную информацию из других источников: анамнеза, результатов других обследований и т.д.
Аллергия на плесень
В процессе исследования проводят определение в сыворотке крови специфических IgE к аллергенам плесени Aspergillus fumigatus.
В процессе исследования проводят определение в сыворотке крови специфических IgE к аллергенам плесени Cladosporium herbarum.
В процессе исследования проводят определение в сыворотке крови специфических IgE к аллергенам плесени Penicillum notatum.
В процессе исследования проводят определение в сыворотке крови специфических IgE к аллергенам плесени Alternaria tenuis.
Синонимы: Аллергия на плесень (грибковая); Аллергия на плесень (микроскопические грибы); Аллергия на плесневые грибки.
Краткое описание исследования «Аллергия на плесень»
Плесневые грибы встречаются практически везде: в жилых домах; в ваннах, душевых комнатах; в почве для домашних растений; на продуктах. Сырые плохо проветриваемые помещения в большей степени подвержены появлению плесени, поскольку повышенная влажность воздуха является благоприятным фактором для активного размножения плесени. Споры грибков легко переносятся воздухом на дальние расстояния. Наибольшая концентрация спор в воздухе отмечается с апреля по ноябрь, в зимние месяцы она минимальна. Сенсибилизация к плесневым грибам может индуцировать развитие аллергических заболеваний: бронхиальной астмы, аллергического ринита и риносинусита, аллергического дерматита.
Краткая характеристика анализов профиля «Аллергия на плесень»
Плесневый гриб Aspergillus fumigatus – возбудитель аспергиллеза, обладает выраженными аллергенными свойствами. Встречается чаще на плодах, имеющих механические повреждения и трещины. В местах поражения поверхность плода загнивает и покрывается пушистым налетом плесени, состоящим из грибницы темного цвета и многочисленных конидиев со спорами. У людей с аллергией к плесневым грибкам возможно развитие перекрестной аллергии при употреблении в пищу продуктов, в процессе изготовления которых применялись процессы ферментации (сыры Рокфор, Блю, Камамбер, вино, шампанское, квас, дрожжевое тесто).
Плесневый гриб Cladosporium herbarum – наиболее часто встречаемый представитель плесени. Размножается на многих органических субстратах, в том числе на бумаге. Обладает выраженными аллергенными свойствами. Паразитирует в основном на растениях, образует споры весной, летом и осенью. Они легко переносятся воздухом и попадают в дыхательные пути, что при наличии предрасполагающих факторов приводит к развитию аллергического заболевания – ринита, бронхиальной астмы, пневмонита. Иммунный ответ на этот аллерген развивается, главным образом, по немедленному типу с участием специфических IgE-антител.
Плесневый гриб Penicillum notatum – источник первого антибиотика – пенициллина. Мицелий зеленого или черного цвета, обладает выраженными аллергенными свойствами. Одна из главных причин возникновения бронхиальной астмы, прежде всего у детей, ринита, атопического дерматита. Споры гриба являются составным компонентом домашней пыли. Попадая в дыхательные пути, могут приводить к развитию аллергических заболеваний. Иммунный ответ на этот аллерген развивается, главным образом, по немедленному типу с участием специфических IgE-антител. При наличии сенсибилизации к Penicillum notatum могут возникать аллергические реакции на введение антибиотиков пенициллинового ряда.
Плесневый гриб Alternaria tenuis (черная гниль) образует налет обычно черного цвета, поражает многие продукты, особенно зерно. Среда обитания в квартирах – преимущественно ванные и душевые комнаты. Сильный аллерген. Может стать причиной атопического дерматита, бронхиальной астмы.
IgE антитела ответственны за развитие аллергических реакций. У людей с аллергическими проявлениями часто (но не всегда) отмечается повышение уровня общего IgE в крови.
С какой целью выполняют исследование «Аллергия на плесень»
Тест используют при наличии аллергоподобных симптомов в целях скрининга для подтверждения/исключения наличия аллергической сенсибилизации к аллергенам плесени.
Аллергия на плесень

Одни виды плесени спасают жизни, другие – убивают. Одни придают особый вкус сырам и винам, другие отравляют наши легкие. Некоторые виды грибов образуются на дереве, другие в ванных комнатах или в книгах. Плесень окружает нас повсюду, и, к сожалению, это опасный аллерген. Аллергия на плесень несет серьезную угрозу здоровью и даже жизни человека. Она может протекать в разной форме, и избавиться от реакций сложно, как и вывести из дома споры плесени.
Плесень – один из самых активных «осенних» аллергенов. Это обусловлено тем, что она предпочитает влажную среду, которая создает для нее самые благоприятные условия для роста и размножения. Аллергия на плесень опасна для здоровья, особенно для детей. Исключить контакт с плесневыми грибами практически невозможно, они размножаются во влажных условиях и тепле, как в домах, так и вне жилых помещений. Чаще всего в квартирах и домах обосновываются грибки рода Penicillium и Aspergillus, их усиленный рост отмечается в осенне-зимний период. Наиболее распространенным местом является ванная комната, но расти они могут и в любых влажных местах помещений – в горшках комнатных растений, кондиционерах, на стенах, малодоступных углах, даже в стиральных машинах и под кухонными мойками. К тому же плесневые грибы активно размножаются в увядших растениях, поэтому у людей с аллергией на плесень симптомы усиливаются именно осенью, когда собирают опавшие листья
Плесень, выделяющая споры, есть везде, даже высоко в горах. Причем грибы без проблем размножаются на любом материале, включая дерево, стекло, пластик, кафель. Слишком маленькие для того, чтобы быть замеченными невооруженным глазом, споры плесени попадают в воздух и затем вдыхаются человеком. Большинство людей не реагируют на эти раздражители, но у восприимчивых людей может развиваться аллергия. У них это может вызвать неприятные симптомы аллергии или проблемы с дыханием, включая астму.
Невидимый враг
В мире насчитывается свыше 300 тысяч видов грибов. Некоторые из них опасны для здоровья и вызывают различные болезни, включая грибковые инфекции и аллергические реакции. Плесень – это один из немногих видов грибов, обитающих во влажных частях дома или на улице. Возможно, вы видели, как она разрастается на продуктах питания, вокруг окон, труб или на крыше. Плесень также может появляться в сырых подвалах или других частях дома, где циркуляция воздуха затруднена, а расти она может где угодно: от старых книг до соломы или опавших листьев. Споры вызывают аллергические реакции при вдыхании, а иногда – при попадании на кожу.
В Украине в жилых помещениях встречаются преимущественно плесневые грибы рода Penicillium, Aspergillus, Cladosporium, реже – Rhizopus. Люди, которые долго находятся в сырых помещениях с большим количеством плесени, подвержены не только повышенным рискам респираторных заболеваний и инфекционного поражения дыхательных путей, но и развитию аллергического ринита, синусита, бронхиальной астмы, которые связаны с сенсибилизацией к плесневым грибам.
- Alternaria alternata – один из самых распространенных плесневых грибов. Повышенная чувствительность к Alternaria может обнаруживаться у пациентов с тяжелым течением бронхиальной астмы и признаками аллергического риноконъюнктивита. Споры этого гриба обнаруживают в воздухе круглый год, с пиковой концентрацией к концу лета и в начале осени.
- Cladosporium herbarum обнаруживают преимущественно вне помещений, а сам гриб обитает на растениях. Концентрация его спор в наших широтах растет в весенне-летне-осенний период и снижается ближе к зиме.
- Aspergillus fumigatus часто выявляют в зернохранилищах, на складах, а также в теплых влажных помещениях. Он играет очень важную роль в развитии аллергического бронхолегочного аспергиллеза, грибкового синусита и ряда других заболеваний.
- Penicillium chrysogenum (также известен как P. notatum) обнаруживается преимущественно в помещениях, в местах хранения продуктов и на складах.
Кто в зоне риска?
Поскольку споры разных видов плесени имеют различное строение, зачастую у людей развивается аллергия на один или несколько видов плесени. Часто развивается перекрестная аллергия с реакцией на продукты питания.
Больше всего подвержены воздействию плесени люди следующих профессий:
- фермеры;
- работники молочных ферм;
- лесорубы;
- пекари;
- рабочие заводов;
- плотники;
- работники теплиц;
- виноделы;
- мастера по ремонту мебели.
Аллергия – это каскад неблагоприятных реакций иммунной системы на аллерген. Эти чрезмерные реакции приводят к выработке антител, воспалительным процессам и неспецифическим симптомам, которые могут включать хрипы, чихание, кашель, зуд, кожную сыпь, боли в животе.
Как проявляется аллергия на плесень?
Симптоматическая картина при аллегии на плесень у взрослых может включать различные проявления.
Симптомы I уровня (специфические):
- высыпания на местах, куда непосредственно попали споры плесени, или же сыпь по всему телу (крапивница);
- кашель или постоянное покашливание, першение в горле и ощущение дискомфорта;
- заложенность носа.
При этом высыпания, вызванные воздействием плесневых грибов, сложно отличить от других типов сыпи. Маловероятно, что вы либо ваш врач сможете диагностировать аллергические высыпания, просто взглянув на них. Сама сыпь может проявляться зудом, сухостью и чешуйчатостью кожи, мокнутиями (мокрая сыпь) и чувствительностью кожи, она может приобретать коричневатый либо розовый оттенок. Возможно также небольших выпуклых неровностей, на верхушке которых может сочиться жидкость.
В целом проявления плесневой аллергии аналогичны признакам других аллергий. Степень реакции может зависеть от уровня сенсибилизации и длительности воздействия аллергена.
Симптомы II уровня (неспецифические). Они выражены сильнее и проявляются после длительного пребывания в среде, где присутствуют аллергены. К симптомам II уровня относятся:
- усталость;
- постоянные головные боли;
- рвота и тошнота;
- потеря аппетита;
- похудение;
- нервные расстройства;
- хронические риносинусит и бронхит.
Постоянное воздействие плесени связано с несколькими потенциальными осложнениями для здоровья, включая астму или ухудшение симптомов астмы, заболевания верхних дыхательных путей и воспаление легких. На начальных этапах симптомы плесневой аллергии напоминают простуду или синусную инфекцию, поскольку их проявления схожи. Уточнить диагноз и подтвердить аллергическую природу заболевания поможет только лабораторная диагностика. Поэтому очень важно грамотно оценить свои силы и не упустить момент выхода ситуации из-под контроля. Лучший способ избежать серьезных осложнений – вовремя обратиться к врачу, который назначит необходимые исследования.
Особенности лабораторной диагностики
Условно плесневые грибы делятся на внешние (которые встречаются в открытом воздухе) и внутренние (паразитируют в помещениях). Однако существуют и виды, которые одинаково распространяются как снаружи, так и внутри помещений. К внутренним относят Cladosporium, Alternaria и Botrytis, к внешним – Aspergillus и Penicillium. Так, аллергия к грибам рода Alternaria является одной из значимых причин бронхиальной астмы, особенно у детей. Поэтому важно выявлять причины появления аллергических симптомов уже на ранних стадиях. Для этого следует обследоваться на наличие/отсутствие аллергии к плесневым грибам.
При повышенной чувствительности организма к определенным видам плесневых грибов наш иммунитет вырабатывает антитела к ним – специфические иммуноглобулины Е (IgE). В портфеле ДІЛА представлен широкий спектр лабораторных исследований для выявления аллергических реакций к плесневым грибам. Это позволяет обнаружить специфические глобулины класса Е к самым распространенным плесневым грибам, чтобы вовремя начать лечение и предотвратить развитие серьезных осложнений.
Предлагаются следующие моноисследования:
- Специфические IgE,Penicillium notatum
- Специфические IgE,Alternaria alternata
- Специфические IgE,Aspergillus fumigatus
- Специфические IgE,Aspergillus niger
- Специфические IgE,Candida albicans
- Специфические IgE,Cladosporium herbarum
- Специфические IgE,Mucor racemosus
В ДІЛА также доступны исследования, обладающие высокой чувствительностью – метод ImmunoCAP ® , признанный мировым стандартом лабораторной диагностики аллергий. ISAC обладает высокой точностью и специфичностью: он позволяет обнаружить в небольшом объеме крови антитела даже в очень низкой концентрации. Технология основана на иммунохемилюминесценции, что повышает чувствительность в несколько раз по сравнению с другими методиками. Флуоресценция измеряется лазерным сканером.
По технологии ImmunoCAP ® выполняются следующие исследования:
- Пакет исследований «Плесень внутренняя» (Aspergillus fumigatus (m3) Aspergillus niger (m207) Mucor racemosus (m4) Penicillium chrysogenum (m1) (P. notatum))
- Пакет исследований «Плесень внешняя» (rAlt a 1 Alternaria alternata (m229) Cladosporium herbarum (m2) Botrytis cinerea (m7))
Обнаружение антител к тому или иному виду плесени позволяет точно определить причину симптомов, связанных с аллергией к ней.
К тому же ДІЛА предлагает мультикомпонентные тесты ALEX 2 и ISAC, которые дают возможность определить наличие аллергии в большинству известных аллергенных белков, включая аллергены плесени. Исследования можно проводить в острый период заболевания, на результаты не влияет прием антигистаминных и гормональных препаратов, топических стероидов и других лекарственных средств. Тесты позволяют проверить наличие сенсибилизации не только к экстрактам, но и к молекулам аллергенов. Это повышает точность и информативность исследования.
Профилактика
Как и любую болезнь, аллергию на плесень легче предотвратить, чем лечить. Борьба с плесневыми грибами начинается с уборки своего жилья. Важно постоянно проверять все потенциальные места развития спор и тщательно их обрабатывать. Фильтры систем кондиционирования следует регулярно чистить, так как они являются значимым фактором распространения плесени по помещениям. Если влажность воздуха превышает 60%, рост плесени происходит быстрее.
Для профилактики придерживайтесь 5 простых правил :
- Избегайте сушки белья в квартире.
- Установите хорошую систему вентиляции в ванной комнате.
- Регулярно проводите уборку.
- Храните продукты в холодильнике или пищевых контейнерах.
- Устраните все протечки труб.
Держите свой дом в чистоте и сухости, тогда развитие аллергии на плесень не будет вам грозить
Лучший способ избежать серьезных осложнений аллергии – вовремя обратиться к врачу. Лабораторная диагностика позволит уточнить диагноз и подтвердить аллергическую природу заболевания. Повторные исследования назначают для оценки эффективности уже проведенной терапии.
Плесень как аллерген. Пищевые аллергены
Плесень как аллерген. Пищевые аллергены
Виды плесени чрезвычайно разнообразны, но аллергенные их свойства доказаны лишь у небольшого числа из них. Основные категории, наиболее тесно связанные с респираторной аллергией, представлены родами Aspergillus, Alternaria, Cladosporium и Penicillium. Для плесени также существуют сезоны максимального спорообразования; составлены календари этих сезонов. Астма, вызываемая плесенью, преобладает в конце лета и осенью. Для разных лиц могут быть важны различные виды плесени, которые следует установить, так как иногда удается уменьшить контакт с ними.
В отличие от пыльцы и аллергенов животных больные редко могут связать свои симптомы с каким-то одним видом вездесущей плесени. Сочетание осеннего обострения симптомов и положительных уколочных тестов с введением плесени может потребовать более детального обследования и, если это необходимо, тестов с провокацией. Например, может наблюдаться резко выраженная сенсибилизация в Меrulius lachrymans (сухая гниль). Эта сенсибилизация может наступить, когда какой-либо человек входит в старый дом или переезжает в пего. Ржавчина различных типов присутствует па злаках, возможно, этим объясняются тяжелые симптомы, наблюдающиеся среди фермеров в конце лета, особенно при сборе урожая комбайнами.
Различные ботанические виды плесени рассматриваются в работе Darke и соавт. (1976).
Споры плесени имеют различный размер, но многие из них малы — около 1—2 им. Это допускает несложное проникновение в легкие, а также длительное сохранение в них. Плесени часто индуцируют образование антител IgG наряду с IgE, что, возможно, связано с проникновением спор в альвеолы. Антигенные компоненты плесени многообразны и сложны. Это очень важно при попытках стандартизировать экстракты. Некоторые антигены, например С. albicans, имеют клеточную стенку, состоящую из полисахаридного маннана, которая окружает белковую соматическую сердцевину, причем и клеточная стенка, и сердцевина могут быть антигенами [Longbottum et al., 1976].
Другие, например A. fumigatus, согласно перекрестному иммуноэлектрофорезу содержат большое количество различных антигенов, которые в некоторой мере зависят от метода культивирования. Длительные поверхностные культуры, поддерживаемые до полного исчезновения, образуют больше антигенов, чем краткосрочные глубокие культуры [Haslam et al., 1976].
Пищевые аллергены. Аллергологи детально изучали пищевые продукты в качестве аллергена. Однако в исследованиях, осуществленных при помощи новых методов, эти продукты привлекали к себе меньше внимания. Обычно для выявления их собирают клинический анамнез, ставят кожные пробы и назначают диету с исключением определенных пищевых продуктов. Пищевые продукты важны для желудочно-кишечной и кожной аллергии. Однако они, вероятно, представляют меньшее значение в качестве аллергена при астме у взрослых. Провоцирующая роль пищевых продуктов была установлена у 17% наших 395 больных. Возможно, что пищевая аллергия, особенно к молоку, яйцу, рыбе и орехам, чаще встречается у детей, и недавно вновь подчеркивалась роль молока животных в возникновении атопии [Soothill et al., 1976].
Была обнаружена также конкордантность между положительными внутрикожными пробами и выделением гистамина из стимулированных периферических лейкоцитов у сенсибилизированных лиц [May, Alberto, 1972]. Напротив, у грудных детей с отрицательными кожными пробами часто наблюдалась трансформация лимфоцитов при воздействии компонентов молока и яиц. Вероятно, это связано с тем, что в начале жизни почти все дети в небольшой мере сенсибилизированы к коровьему молоку [Kletter et al., 1971]. К величайшему огорчению многих взрослых людей, было доказано, что разнообразные спиртные напитки индуцируют астму [Breslin et al., 1973]. Вид спиртного напитка часто бывает специфическим для данного человека. Этиловый спирт сам по себе безвреден (в отношении астмы!), однако вредный спиртной напиток вызывает астму, даже если он вводится прямо в желудок через желудочный зонд так, чтобы избежать случайной ингаляции. К счастью, вызванная алкоголем астма часто предупреждается предварительным вдыханием гликата натрия-хрома [Breslin et al., 1973].
- Вернуться в оглавление раздела "Пульмонология."
Информация на сайте подлежит консультации лечащим врачом и не заменяет очной консультации с ним.
См. подробнее в пользовательском соглашении.
Сенсибилизация к аллергенам плесневых грибов у пациентов с респираторной аллергией. Оптимизация диагностического процесса
Актуальность. В Болгарии часто встречается аллергия на плесневые грибы, сенсибилизация к различным аллергенам грибов обнаруживается у многих пациентов с атопией.
Цель данного исследования — установить чувствительность к наиболее распространенным видам плесневых грибов в Болгарии и определить с помощью компонентной диагностики наличие сенсибилизации к Alt a1 - одному из главных аллергенов Alternaria alternata.
Материалы и методы. В обследование включен 21 пациент с респираторной аллергией в возрасте 5-40 лет. Сенсибилизация к микстам грибковых аллергенов, содержащих Alternaria alternata, Aspergillus sp., Cladosporium herbarum, Penicillium notatum, у всех пациентов доказана посредством диагностики in vivo и in vitro. Кроме того, все пациенты тестированы с помощью «ImmunoCAP» на наличие аллергенспецифических IgE к отдельным грибковым аллергенам: m1 Penicillium notatum, m2 Cladosporium herbarum, m3 Aspergillus fumigatus и m6 Alternaria alternata. У 10 из обследованных пациентов с повышенным sIgE к m6 Alternaria alternata проведена компонентная диагностика с помощью Alt a1.
Результаты. Все обследованные пациенты имели повышенный уровень sIgE к Alternaria alternata. Из них 10 (48%) пациентов проявили чувствительность только к Alternaria alternata. У 8 (38%) пациентов выявлена сенсибилизация к Penicillium notatum, у 11 (52%) - к Cladosporium herbarum и у 10 (48%) - к Aspergillus fumigatus; 9 (90%) пациентов с сенсибилизацией к Alternaria alternata имели повышенный уровень IgE к Alt a1.
Выводы. Alternaria alternata чаще других видов плесневых грибов вызывает сенсибилизацию у пациентов с респираторной аллергией в Болгарии. Компонентная аллергодиагностика с использованием Alt a1 - главного аллергена плесени - дает полное доказательство видоспецифической сенсибилизации к Alternaria alternata.
Ключевые слова
Введение
Плесневые грибы являются существенным компонентом биоаэрозолей окружающей среды, и многие их аллергены связывают с аллергическими заболеваниями человека, в том числе с аллергическим ринитом, конъюнктивитом, бронхиальной астмой и аллергическим бронхолегочным микозом. В этом плане плесени оказывают более значимое воздействие на иммунную систему пациента, чем пыльца или другие бытовые аллергены [1]. Из-за благоприятных климатических условий аллергия на плесень часто встречается в Болгарии, и сенсибилизация к плесневым грибам обнаруживается у многих пациентов с атопией. Основные виды плесневых грибов, которые чаще всего вызывают сенсибилизацию в стране, — это Cladosporium, Alternaria, Penicillium и Aspergillus. Ранее мы показали, что 6% взрослых и детей, тестированных за последние 5 лет в отделе аллергологии, были моносенсибилизированы к плесневым аллергенам [2, 3]. Аллергия на плесень может быть диагностирована при помощи кожно-аллергических проб (приктест или интрадермальный тест) с аллергенными экстрактами из плесени или in vitro тестами определения в сыворотке крови специфических IgE к плесневым аллергенам. К сожалению, среди плесневых экстрактов аллергенов часто встречается перекрестная реактивность. Это явление уменьшает точность анализа, в связи с чем необходимы ясные алгоритмы прецизионной диагностики аллергии на плесени [4, 5]. Для преодоления ограничений в диагностике на основе натуральных аллергенных экстрактов в последнее время в Европе применяют новый in vitro метод молекулярной, или компонентной, диагностики аллергии (CRD), который использует индивидуальные рекомбинантные или нативные аллергенные молекулы. Тесты осуществляются посредством флюоресцентного иммуноанализа автоматической системой («ImmunoCAP») или на основе мультиплексных микрочиповых методик [6].
Целью данного исследования является изучение сенсибилизации к наиболее распространенным видам плесневых грибов в Болгарии, а также определение посредством CRD степени сенсибилизации к Alt a1 — главному аллергену Alternaria alternata.
Материалы и методы
В исследование включен 21 пациент (14 человек мужского пола и 7 — женского, в возрасте 5-40 лет), у которых выявлены симптомы респираторной аллергии. У 7 из них был аллергический ринит, у 9 — бронхиальная астма, а у 5 — бронхиальная астма в сочетании с аллергическим ринитом. У всех пациентов обнаружен положительный кожный тест к групповому фунгальному аллергену Д1 («Bul Bio NCIPD», Болгария), содержащему Alternaria alternata, Aspergillus sp., Cladosporium herbarum, Penicillium notatum. В сыворотке крови у всех пациентов выявлен повышенный уровень аллергенспецифических IgE (sIgE) к миксту плесневых аллергенов Mxl (класс 2-4), содержащему Penicillium notatum, Cladosporium herbarum, Alternaria alternata и Aspergillus fumigatus («Phadia»).
У пациентов, включенных в исследование, определяли с помощью «ImmunoCAP» наличие sIgE к следующим индивидуальным натуральным плесневым аллергенам: ml Penicillium notatum, m2 Cladosporium herbarum, m3 Aspergillus fumigatus и m6 Alternaria alternata («Phadia»). Исследование проводили согласно инструкции производителя, при этом количество специфического sIgE выражали в KUA/L, где уровень выше 0,35 KUA/L считался повышенным.
В сыворотках 10 пациентов с повышенным sIgE к m6 Alternaria alternata (5 — с моносенсибилизацией и 5 — с полисенсибилизацией к другим плес невым аллергенам) посредством «ImmunoCAP» определяли sIgE к m229 Alt a1 («Phadia»).
Результаты обработаны при помощи пакета статистических программ «GraphPad Prism 6.0» («GraphPad Software, Inc.»). Подсчитана средняя величина (M) и стандартная ошибка среднего (SEM). Тест ранговой корреляции Спирмена использован для выявления связи между двумя количественными показателями — количеством sIgE к m6 Alternaria alternata и sIgE к m229 Alt a1. Статистически значимыми приняты значения при р < 0,055.
Результаты
Полученные обобщенные уровни sIgE к индивидуальным аллергенным экстрактам исследованных видов плесени представлены на рис. 1.

Рис. 1. Определение sIgE к индивидуальным алергенным экстрактам плесневых грибов.
Fig. 1. Determination of sIgE to individual allergenic mold extracts
У всех обследованных пациентов выявлен повышенный уровень sIgE к Alternaria alternata — в среднем 15,84 ± 8,52 KUA/L. Восемь (38%) пациентов оказались сенсибилизированы к Penicillium notatum со средним уровнем sIgE 1,46 ± 0,73 KUA/L. У 11 (52%) пациентов выявлены также sIgE к Cladosporium herbarum и у 10 (48%) — к Aspergillus fumigatus в количестве 2,79 ±1,83 и 3,08 ± 2,31 KUA/L соответственно.
При анализе данных каждого пациента получены следующие профили сенсибилизации (таблица), позволившие разделить пациентов на 2 основные группы:
- 10 (48%) пациентов оказались моносенсибилизированными к Alternaria alternata;
- 11 (52%) пациентов были чувствительны к более чем одному виду плесени, при этом 8 (38%) из них имели sIgE к 4 тестированным плесневым аллергенам.
Профили сенсибилизации к исследова нным плесневым аллергенам у пациентов с респираторной аллергией
Sensitization profiles to the studied fungal allergens in patients with respiratory allergy
Профили сенсибилизации Sensitization profile
Число пациентов Number of patients
У 10 пациентов с сенсибилизацией к Alternaria alternata была проведена монокомпонентная молекулярная диагностика аллергии на Alternaria alternata с использованием рекомбинантного Alt a1 аллергена (rAlt a1). Результаты исследования представлены на рис. 2.

Рис. 2. Сравнение уровней sIgE к натуральному экстракту Alternaria alternata (m6) и sIgE к rAlt a1, полученных методом молекулярной диагностики пациентов с респираторной аллергией.
Fig. 2. Comparison of the amounts of sIgE to crude extract of Alternaria alternata (m6) and results of CRD with rAlt a 1 in patients with respiratory allergy.
Полученные данные показали, что 9 (90%) пациентов с сенсибилизацией к Alternaria alternata имеют повышенный уровень sIgE к rAlt a1. Тест ранговой корреляции Спирмена показал высокую (rS = 0,9152) положительную и статистически значимую корреляцию (р = 0,0003) между сывороточным уровнем IgE к m6 Alternaria alternata и к rAlt a1 у обследованных пациентов.
Исследования, проведенные в разных частях мира, показали, что сверхчувствительность к плесени встречается часто, особенно среди индивидов с респираторной аллергией. Точная величина распространения сенсибилизации к плесени неизвестна, цифры варьируют от 3 до 10% общей популяции [7]. Наиболее часто с развитием аллергии связаны 4 рода плесневых грибов: Alternaria, Cladosporium, Penicillium и Aspergillus [8]. В результате многих исследований установлено, что Alternaria alternata является одним из наиболее важных плесневых грибов, вызывающих аллергию в Европе, и до 70% пациентов показывают положительный кожный тест на Alternaria alternata. Кроме того, доказано, что он является фактором риска развития астмы 7. Наше исследование также показало, что большинство пациентов с аллергией к плесени сенсибилизированы преимущественно к Alternaria alternata, и у 48% из них выявлена моносенсибилизация. Остальные 52% пациентов были сенсибилизированы более чем к одному виду плесени, а 38% из них имели sIgE ко всем 4 исследованным плесневым аллергенам. Это еще раз подтверждает наблюдение многих исследователей, что пациенты, чувствительные к плесени, скорее всего, сенсибилизированы к нескольким ее видам [3, 4, 8].
Современная постановка диагноза аллергии на плесневые грибы является поэтапным процессом, который включает сбор анамнеза, кожно-аллергическое тестирование, определение общих и аллергенспецифических IgE в сыворотке крови и, если необходимо, проведение провокационных тестов [10]. Для повышения точности диагноза аллергии на плесень все чаще используют метод молекулярной, или компонентной, аллергодиагностики с отдельными рекомбинантными или естественными аллергенными молекулами. Alt а1 — это аллергенная молекула Alternaria alternata, которую распознают антитела к IgE у 80-90% пациентов с аллергией на Alternaria [11]. Это и определяет Alt а1 как мажорный аллерген, к которому в основном сенсибилизированы пациенты. Поскольку молекула Alt a1 уникальна для данного вида плесневого гриба, сенсибилизация к этому аллергену определяется как видоспецифическая для Alternaria alternata [12, 13]. Таким образом, наличие сенсибилизации к Alt а1 можно использовать как маркер точности доказательства аллергии на данный вид плесени [14, 15].
Наши результаты монокомпонентной молекулярной диагностики при помощи rAlt a1 показывают, что 90% обследованных пациентов с сенсибилизацией к Alternaria имеют повышенный уровень IgE к rAlt a1 с высокой положительной (rS = 0,9152; р = 0,0003) корреляцией с сывороточным уровнем IgE к Alternaria.
Одно из последних исследований, включающее 80 европейских пациентов, показало, что rAlt a1 может быть использован для диагностики 98% пациентов с аллергией на Alternaria alternata и что почти все специфические IgE у этих пациентов направлены против Alt a1 [16]. Такое заключение предполагает, что Alt а1 можно использовать в качестве надежного диагностического маркера видоспецифической сенсибилизации к Alternaria и он может быть альтернативой натуральному экстракту Alternaria в диагностических in vitro панелях.
Естественный аллергенный экстракт Alternaria alternata содержит и другие аллергенные молекулы, некоторые из которых тоже могут быть идентифицированы как мажорные аллергены [17]. Например, Alt a2 (альдегиддегидрогеназа) — видоспецифический аллерген и Alt а5 (энолаза) — паналлерген, который находится в некоторых фунгальных аллергенных экстрактах [18]. Перекрестная реактивность Alternaria alternata с другими видами плесневых грибов, которые распространяются воздушным путем, подробно описана и может быть обусловлена другими аллергенными молекулами [19]. Есть доказательства, что значительная доля пациентов, чувствительных к Alternaria alternata, полисенсибилизирована к более чем одному виду плесневых грибов и может также быть сенсибилизирована к другим источникам аэроаллергенов в окружающей среде: пыльце, клещам или даже пищевым аллергенам [8]. По-видимому, наличие такого высокого процента полисенсибилизации к различным видам плесневых грибов у пациентов, включенных в настоящее исследование, может быть вызвано перекрестной реактивностью.
Заключение
Alternaria alternata чаще всего приводит к сенсибилизации у пациентов с респираторной аллергией. Уровень аллергенспецифических IgE к данному виду плесневого гриба наиболее высокий и наблюдается в большом проценте случаев у пациентов с моносенсибилизацией. Молекулярную компонентную диагностику с помощью rAlt а1 можно использовать как маркер для доказательства видовой сенсибилизации к Alternaria alternata. Более того, этот рекомбинантный аллерген может быть альтернативой использованию натурального экстракта Alternaria в диагностических in vitro панелях. Идентификация и характеристика полного спектра аллергенов Alternaria и разработка новых методов, основанных на аллергенных рекомбинантных белках, позволит получать более качественные тестовые решения для улучшения диагностики аллергии на Alternaria alternata и другие плесневые грибы.
Список литературы
2. Nikolov G., Kandova Y., Hristova R., Nedyalkov M., Petrunov B. The role of fungal allergens in respiratory diseases in Bulgaria. In: Allergy, Asthma & Immunology: From Basic Science to Clinical Application. Proceedings of the V World Asthma and COPD Forum. New York; 2012: 47-54.
13. Duffort O., Barber D., Polo F. Quantification assay for the major allergen in Alternaria alternata, Alt a1. Alergol. Inmunol. Clin. 2002; 17(3): 162-172.
Читайте также:
